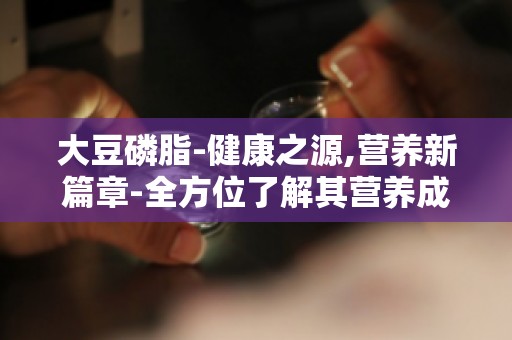

大豆磷脂-健康之源,营养新篇章-孕妇、儿童等特殊人群的补充之道
在繁忙的都市生活中,我们总是追求健康与活力,却往往忽略了那些默默无闻的营养守护者。今天,就让我们揭开大豆磷脂的神秘面纱,探寻它在孕妇、儿童等特殊人群中的补充之道,开启一段全新的健康之旅。

一、大豆磷脂:健康之源
大豆磷脂,被誉为“生命活力素”,是一种天然的生物活性物质。它广泛存在于大豆、蛋黄、小麦胚芽等食物中,尤其在大豆中含量丰富。大豆磷脂具有多种生理活性,如抗氧化、抗炎、降血脂、保护心血管等,对人体健康具有重要作用。
二、大豆磷脂:孕妇的营养守护者
孕妇是特殊人群,她们不仅要为自己的健康负责,还要为胎儿的生长发育提供充足的营养。大豆磷脂在孕妇营养补充中具有以下优势:
1. 促进胎儿大脑发育:大豆磷脂中的卵磷脂是胎儿大脑发育的重要物质,能促进胎儿神经系统的发育,提高智力水平。
2. 增强孕妇免疫力:大豆磷脂具有抗氧化、抗炎作用,能提高孕妇免疫力,降低孕期感染风险。
3. 改善孕期便秘:大豆磷脂具有润肠通便的作用,能有效缓解孕期便秘问题。
4. 降低孕期高血压风险:大豆磷脂具有降血脂、保护心血管的作用,能降低孕期高血压风险。
三、大豆磷脂:儿童的健康伴侣
儿童是祖国的未来,他们的健康成长关系到国内的发展。大豆磷脂在儿童营养补充中具有以下作用:
1. 促进儿童大脑发育:大豆磷脂中的卵磷脂是儿童大脑发育的重要物质,能提高儿童智力水平。
2. 增强儿童免疫力:大豆磷脂具有抗氧化、抗炎作用,能提高儿童免疫力,降低患病风险。
3. 改善儿童视力:大豆磷脂中的叶黄素具有保护视网膜、改善视力的作用。
4. 促进儿童身高增长:大豆磷脂中的钙、磷等矿物质有助于儿童骨骼发育,促进身高增长。
四、大豆磷脂:营养新篇章
随着人们对健康饮食的重视,大豆磷脂作为一种天然、安全的营养补充剂,越来越受到人们的青睐。在孕妇、儿童等特殊人群的饮食中添加大豆磷脂,不仅能为他们提供充足的营养,还能助力他们健康成长。
大豆磷脂作为一种健康之源,为孕妇、儿童等特殊人群提供了丰富的营养补充。让我们共同关注大豆磷脂,开启一段全新的健康之旅,为我国人民的健康事业贡献力量。